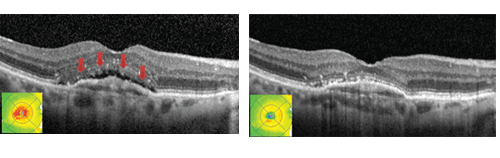

Eylea: 阿柏西普--治療老年黃斑退化更有效
2016/08/23 09:34
瀏覽261
迴響0
推薦2
引用0
黃斑部是位於視網膜中心的一個區域,是視覺最敏銳的部位。一旦有病變或損傷,視力會急速減退,眼睛看到的影像的中心會變暗或扭曲,給日常生活帶來極大困擾,嚴重時甚至失明。

在已發展國家和香港,老年黃斑退化(Age-related Macular Degeneration,AMD)已經取代白內障和青光眼,成為老年人頭號的致盲原因。老年黃斑退化通常破壞中央視力,早期病人癥狀多數不明顯,而到晚期中央視力被破壞,就可能出現中央視力明顯下降。有兩種不同類型的AMD:乾性/非出血性老年黃斑退化:有小型黃色沈積物,被稱為玻璃體疣(drusen),會在黃斑區的視網膜色素層下積聚起來。表現為較輕的視力破壞及較好的預後,有90%的AMD病人患有幹性黃斑退化;濕性老年黃斑退化:新的血管在黃斑部內的區域開始增長,由於多數合併黃斑區域的出血、滲出,可導致中央視力在很短的時間內受到損害。雖然這種類型的AMD只會影響大約10%的患者,但有90%會造成與AMD有關的嚴重視力喪失。
根據最新的研究顯示,在50歲及以上的中國人群中,早期老年黃斑退化的患病率與白種人相若;但是,中國人中的濕性老年黃斑退化居然比明顯比西方人更多。另外有一種息肉狀脈絡膜血管病變(Polypoidal Choroidal Vasculopathy, PCV),是一種好發在黑人及亞洲人的特殊形態的濕性老年黃斑退化,經常造成反復性的視網膜下出血甚至玻璃體出血,對視力的損傷更為嚴重。

老年黃斑退化的治療
乾性老年黃斑退化目前並無較積極的治療方式。主要以生活型態的改變及飲食的補充為主。戒煙(包括避開二手煙)是最重要的預防工作。其他如血壓、血糖,血脂皆要控制良好。在強光下應戴太陽眼鏡以避免紫外線對眼睛的損傷。另外,有研究表明,如一隻眼患有嚴重的黃斑退化,口服一些營養補充劑,包括多種微量元素及維他命類等,可延緩另一隻眼患上黃斑退化的風險。
濕性老年黃斑退化治療挑戰很大。研究顯示應用光動力治療可有效阻止嚴重的視力喪失,然而長期治療效果欠理想。相對地,玻璃體腔內注射抗血管內皮生長因數(Ranibizumab或Lucentis? ,樂明睛和Bevacizumab或Avastin?,癌思停)藥物則可以有效穩定病情,甚或提升視力。兩項國際大型研究(MARINA 和ANCHOR研究)顯示,超過90%的接受玻璃體腔內注射抗血管內皮生長因數(anti-VEGF)藥物治療的患者視力趨於穩定。
但是,眼內注射anti-VEGF藥物依然存在一定的風險。其一,需要反復每月注射以便維持療效,這將導致較高的治療費用,並增加了病人的心理負擔;其二,注射屬於入侵性治療,極少數病人會出現嚴重眼內併發癥如眼內炎和視網膜脫落等的風險,而如果注射次數增多則出現併發癥的風險也相應提高。
治療新藥面世可能帶來新的選擇
針對老年黃斑退化的新藥研發一直是國際眼科的尖新領域,目的是研發療效更好,維持治療效果更長,風險更低的新藥。2011年,美國食品藥品監督管理局批準了一種新的anti-VEGF藥物(EYLEA? ,aflibercept),用於治療濕性老年黃斑退化。
Eylea又叫做VEGF Trap-Eye,是一種新型玻璃體內注射用VEGF抑制劑,是一種重組融合蛋白,由人血管內皮細胞生長因數(VEGF)受體1和2的胞外區與人免疫球蛋白G1的可結晶片段融合而成。Eylea作為VEGF家族各成員(包括VEGF-A)及胎盤生長因數(PIGF)的一種可溶性誘餌受體發揮作用,與這些因數具有極高的親和力,從而抑制這些因數與同源VEGF受體的結合,因此Eylea可抑制異常的血管生成及滲漏。
玻璃體腔注射Eylea的安全性和療效已在2項針對濕性AMD患者的隨機、多中心、雙盲、陽性對照研究中得到了評估。其結果表明,與治療濕性黃斑退化的常用方法相比,即每個月注射anti-VEGF藥物,玻璃體注射Eylea,前三個月採用每月注射,之後可相隔8個星期注射,在維持或改善視力方面與常用的anti-VEGF藥物療效相若。亦有個別的臨床病例研究報告顯示,使用Eylea,可治癒已經對Lucentis (樂明睛)或Avastin (癌思停)治療效果不佳的病例(圖2)。Eylea比其他anti-VEGF藥物,減少玻璃體內注射次數,降低因注射而帶來的併發癥的風險;減少病人的就診次數以及其經濟負擔,但其長期治療效果及副作用則需要更多的臨床數據。
結語:
濕性黃斑退化的治療至今在眼科領域仍是一大難題。玻璃體腔內注射anti-VEGF藥物(Lucentis,樂明睛或Avastin癌思停)可以使得濕性黃斑退化趨於穩定甚或改善。最新的anti-VEGF藥物(Eylea)應用於臨床,為老年黃斑退化的治療帶來一個新的選擇,但其是否亦能夠產生更佳的治療效果,則有待進一步的研究來驗證。
歡迎加入:https://www.facebook.com/dennislameyecenter/ 林順潮眼科中心
你可能會有興趣的文章:
限會員,要發表迴響,請先登入




